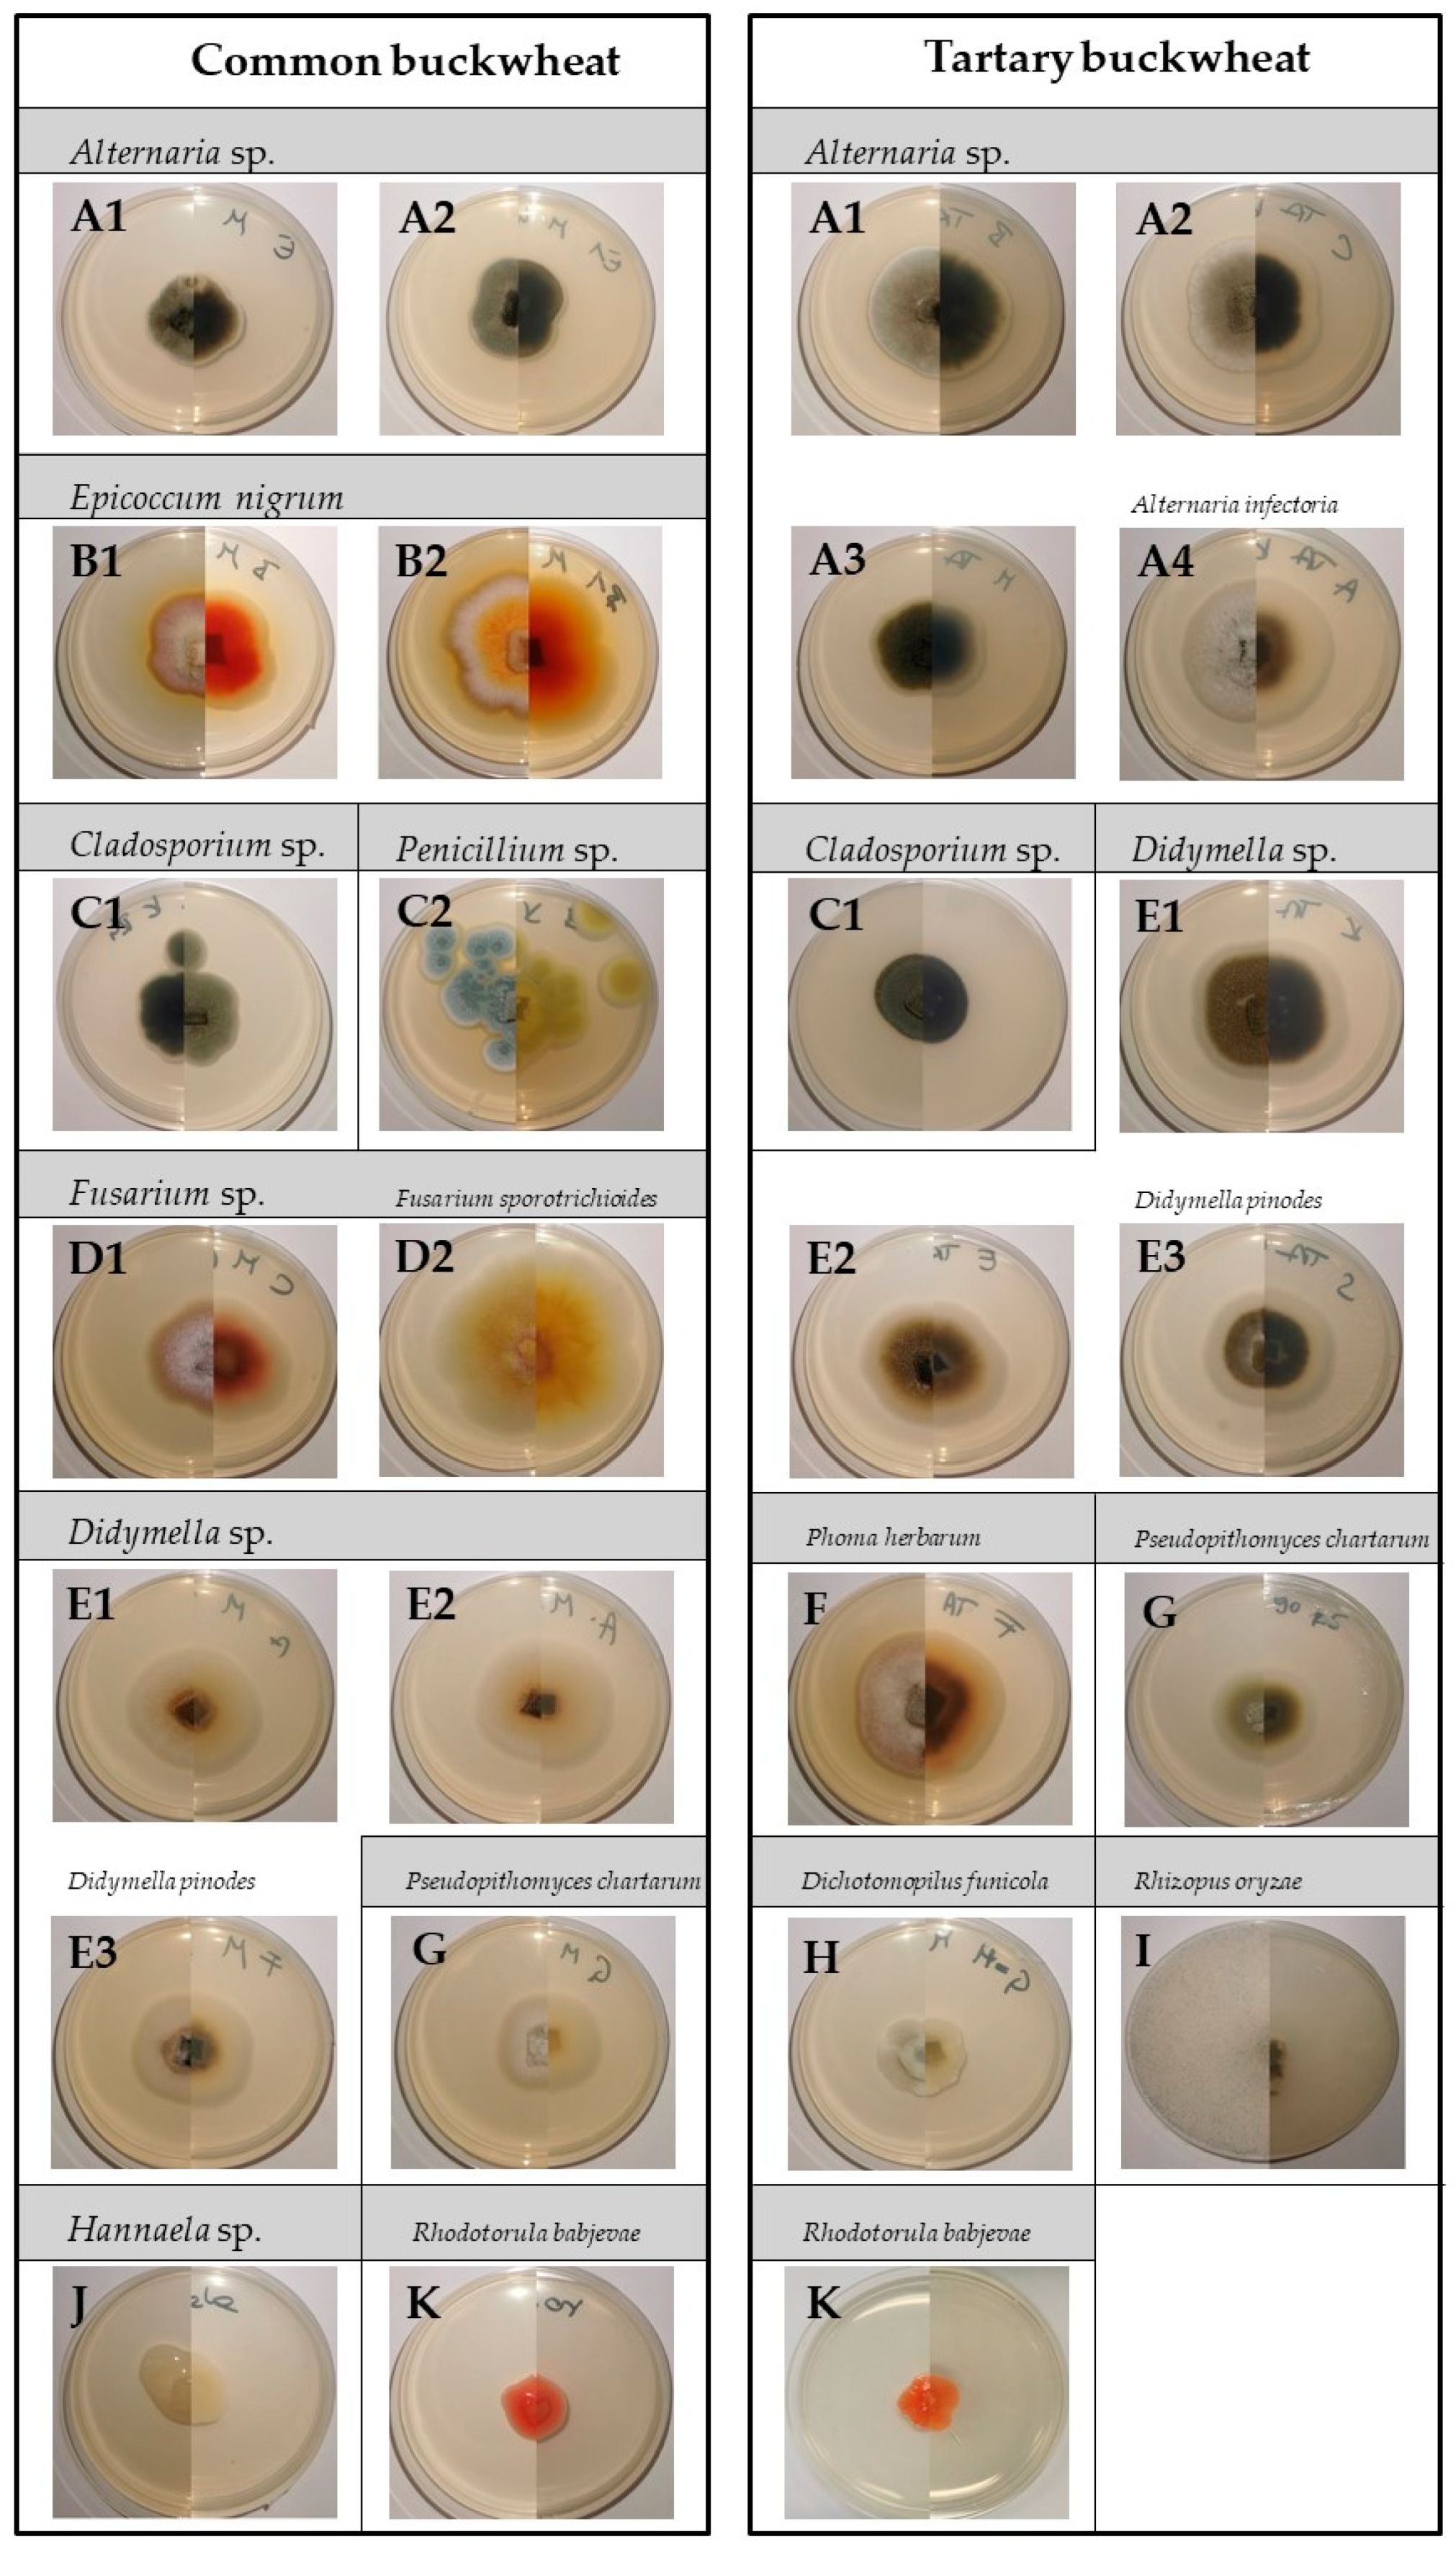
Plants 10 00851 g006 Plants 10 00851 g006

Cold Plasma Affects Germination and Fungal Community Structure of Buckwheat Seeds
Abstract
1. Introduction
2. Results
2.1. Effect of CP Treatment on Seed Germination
2.2. Effect of Cold Plasma Treatment on Buckwheat Seed-Borne Fungi
2.2.1. Fungal Colonisation
2.2.2. Fungal Diversity
3. Discussion
3.1. Effect of Cold Plasma Treatment on Seed Germination
3.2. Effect of Cold Plasma Treatment on Fungal Decontamination
3.3. Effect of Cold Plasma Treatment on Fungal Diversity
4. Materials and Methods
4.1. Buckwheat Seeds Origin
4.2. Cold Plasma Treatment
4.3. Germination Test
4.4. Effect of CP on Seed-Borne Fungi Decontamination
4.5. Cultivation of Seed-Borne Fungi
4.6. Seed Colonisation and Morphological Characterisation of Fungi
4.7. Molecular Identification
4.8. Statistical Analysis
5. Conclusions
Supplementary Materials
Author Contributions
Funding
Data Availability Statement
Acknowledgments
Conflicts of Interest
References
- Kay, J.G.; Owen, H. Transmission of Rhynchosporium secalis on barley grain. Trans. Br. Mycol. Soc. 1973, 60, 405–411. [Google Scholar] [CrossRef]
- Rioux, R.A.; Shultz, J.; Garcia, M.; Willis, D.K.; Casler, M.; Bonos, S.; Smith, D.; Kerns, J. Sclerotinia homoeocarpa Overwinters in turfgrass and is present in commercial seed. PLoS ONE 2014, 9, e110897. [Google Scholar] [CrossRef] [PubMed]
- Christensen, C.M. Deterioration of stored grains by fungi. Bot. Rev. 1957, 23, 108–134. [Google Scholar] [CrossRef]
- Halloin, J.M. Deterioration resistance mechanisms in seeds. Phytopathology 1983, 73, 335–339. [Google Scholar] [CrossRef]
- Bonafaccia, G.; Marocchini, M.; Kreft, I. Composition and technological properties of the flour and bran from common and tartary buckwheat. Food Chem. 2003, 80, 9–15. [Google Scholar] [CrossRef]
- Bonafaccia, G.; Fabjan, N. Nutritional comparison of tartary buckwheat with common buckwheat and minor cereals. Zb. Bioteh. Fak. Univ. Ljublj. Kmet 2003, 81, 349–355. [Google Scholar]
- Bonafaccia, G.; Gambelli, L.; Fabjan, N.; Kreft, I. Trace elements in flour and bran from common and tartary buckwheat. Food Chem. 2003, 83, 1–5. [Google Scholar] [CrossRef]
- Kreft, I.; Fabjan, N.; Yasumoto, K. Rutin content in buckwheat (Fagopyrum esculentum Moench) food materials and products. Food Chem. 2006, 98, 508–512. [Google Scholar] [CrossRef]
- Skerritt, J.H. Molecular comparison of alcohol-soluble wheat and buchwheat proteins. Cereal Chem. 1986, 63, 365–369. [Google Scholar]
- Kalinova, J.; Triska, J.; Vrchotova, N. Distribution of vitamin e, squalene, epicatechin, and rutin in common buckwheat plants (Fagopyrum esculentum Moench). J. Agric. Food Chem. 2006, 74, 5330–5335. [Google Scholar] [CrossRef]
- Popović, V.; Sikora, V.; Berenji, J.; Filipović, V.; Dolijanović, Ž.; Ikanović, J.; Dončić, D. Analysis of buckwheat production in the world and Serbia. Ekon. Poljopr. 2014, 61, 53–62. [Google Scholar] [CrossRef]
- Los, A.; Ziuzina, D.; Akkermans, S.; Boehm, D.; Cullen, P.J.; Van Impe, J.; Bourke, P. Improving microbiological safety and quality characteristics of wheat and barley by high voltage atmospheric cold plasma closed processing. Food Res. Int. 2018, 106, 509–521. [Google Scholar] [CrossRef]
- Misra, N.; Schluter, O.; Cullen, P. Cold Plasma in Food and Agriculture, 1st ed.; Academic Press: Cambridge, MA, USA, 2016; ISBN 9780128013656. [Google Scholar]
- Selcuk, M.; Oksuz, L.; Basaran, P. Decontamination of grains and legumes infected with Aspergillus spp. and Penicillum spp. by cold plasma treatment. Bioresour. Technol. 2008, 99, 5104–5109. [Google Scholar] [CrossRef]
- Milevoj, L. Buckwheat diseases. In Fagopyrum (Buckwheat newsletter); Kreft, I., Ed.; Biotehniška Fakulteta: Ljubljana, Yugoslavia, 1989; Volume 9, pp. 31–40. [Google Scholar]
- Kovačec, E.; Likar, M.; Regvar, M. Temporal changes in fungal communities from buckwheat seeds and their effects on seed germination and seedling secondary metabolism. Fungal Biol. 2016, 120, 666–678. [Google Scholar] [CrossRef]
- Mills, J.T.; Wallace, H.A.H. Microflora of buckwheat seed, changes in storage and effect of seed treatments on seedling emergence. Can. Plant Dis. Surv. 1971, 51, 154–158. [Google Scholar]
- Singh, P.N.; Sindhu, I.R.; Singhal, G. Fungi recorded from seeds and seedlings of Fagopyrum esculentum. J. Indian Bot. Soc. 1984, 63, 236–243. [Google Scholar]
- Fung, F.; Clark, R.F. Health effects of mycotoxins: A toxicological overview. J. Toxicol. Clin. Toxicol. 2004, 42, 217–234. [Google Scholar] [CrossRef] [PubMed]
- Paterson, R.R.M.; Lima, N. Toxicology of Mycotoxins; Luch, A., Ed.; Birkhäuser: Basel, Switzerland, 2010; Volume 100. [Google Scholar]
- Logrieco, A.; Moretti, A.; Solfrizzo, M. Alternaria toxins and plant diseases: An overview of origin, occurrence and risks. World Mycotoxin J. 2009, 2, 129–140. [Google Scholar] [CrossRef]
- Miller, J.D. Fungi and mycotoxins in grains: Implication for stored roducts research. J. Stored Prod. Res. 1995, 31, 1–16. [Google Scholar] [CrossRef]
- Ostry, V. Alternaria mycotoxins: An overview of chemical characterization, producers, toxicity, analysis and occurrence in foodstuffs. World Mycotoxin J. 2008, 1, 175–188. [Google Scholar] [CrossRef]
- Soriano, J.M.; Dragacci, S. Occurrence of fumonisins in foods. Food Res. Int. 2004, 37, 985–1000. [Google Scholar] [CrossRef]
- FAO United Nations. How to Feed the World in 2050 Executive; FAO United Nations: Rome, Italy, 2009. [Google Scholar]
- Piel, A. Plasma Physics; Springer: Berlin/Heidelberg, Germany, 2010; Volume 53, ISBN 9788578110796. [Google Scholar]
- Tendero, C.; Tixier, C.; Tristant, P.; Desmaison, J.; Leprince, P. Atmospheric pressure plasmas: A review. Spectrochim. Acta Part B At. Spectrosc. 2006, 61, 2–30. [Google Scholar] [CrossRef]
- Conrads, H.; Schmidt, M. Plasma generation and plasma sources. Plasma Sources Sci. Technol. 2000, 9, 441–454. [Google Scholar] [CrossRef]
- Filatova, I.; Azharonok, V.; Gorodetskaya, E.; Mel, L.; Shedikova, O.; Shik, A. Plasma-Radiowave Stimulation of Plant Seeds Germination and Inactivation of Pathogenic Microorganisms. IPSC_19. 2009, pp. 4–7. Available online: https://www.semanticscholar.org/paper/Plasma-radiowave-stimulation-of-plant-seeds-and-of-Filatova-Azharonok/503c47acd4f1b4008ec50a6fbf4aac47eb9fe940 (accessed on 3 February 2021).
- Mitra, A.; Li, Y.; Klämpfl, T.G.; Shimizu, T.; Jeon, J.; Morfill, G.E.; Zimmermann, J.L. Inactivation of surface-borne microorganisms and increased germination of seed specimen by cold atmospheric plasma. Food Bioprocess Technol. 2014, 7, 645–653. [Google Scholar] [CrossRef]
- Randeniya, L.K.; De Groot, G.J.J.B. Non-thermal plasma treatment of agricultural seeds for stimulation of germination, removal of surface contamination and other benefits: A review. Plasma Process. Polym. 2015, 12, 608–623. [Google Scholar] [CrossRef]
- Živković, S.; Puač, N.; Giba, Z.; Grubišić, D.; Petrović, Z.L. The stimulatory effect of non-equilibrium (low temperature) air plasma pretreatment on light-induced germination of Paulownia tomentosa seeds. Seed Sci. Technol. 2004, 32, 693–701. [Google Scholar] [CrossRef]
- Volin, J.C.; Denes, F.S.; Young, R.A.; Park, S.M.T. Modification of seed germination performance through cold plasma chemistry technology. Crop Sci. 2000, 40, 1706–1718. [Google Scholar] [CrossRef]
- Henselová, M.; Slováková, Ľ.; Martinka, M.; Zahoranová, A. Growth, anatomy and enzyme activity changes in maize roots induced by treatment of seeds with low-temperature plasma. Biologia 2012, 67, 490–497. [Google Scholar] [CrossRef]
- Bormashenko, E.; Grynyov, R.; Bormashenko, Y.; Drori, E. Cold radiofrequency plasma treatment modifies wettability and germination speed of plant seeds. Sci. Rep. 2012, 2. [Google Scholar] [CrossRef]
- Filatova, I.; Azharonok, V.; Shik, A.; Antonuk, A.; Terletskaya, N. Fungicidal Effects of Plasma and Radio-Wave Pre-treatments on Seeds of Grain Crops and Legumes. NATO Sci. Peace Secur. Ser. A Chem. Biol. 2012, 469–479. [Google Scholar] [CrossRef]
- Filatova, I.; Azharonok, V.; Lushkevich, V.; Zhukovsky, A.; Gadzhieva, G.; Spasi, K. Plasma Seeds Treatment as a Promising Technique for Seed Germination Improvement. 31st ICPIG. 2013, pp. 4–7. Available online: https://www.semanticscholar.org/paper/Plasma-seeds-treatment-as-a-promising-technique-for-Filatova-Azharonok/5e45e5f0a890d8e65a4936292d55173fdddd6c95 (accessed on 3 February 2021).
- Zahoranová, A.; Henselová, M.; Hudecová, D.; Kaliňáková, B.; Kováčik, D.; Medvecká, V.; Černák, M. Effect of cold atmospheric pressure plasma on the wheat seedlings vigor and on the inactivation of microorganisms on the seeds surface. Plasma Chem. Plasma Process. 2016, 36, 397–414. [Google Scholar] [CrossRef]
- Zahoranová, A.; Hoppanová, L.; Šimončicová, J.; Tučeková, Z.; Medvecká, V.; Hudecová, D.; Kaliňáková, B.; Kováčik, D.; Černák, M. Effect of cold atmospheric pressure plasma on maize seeds: Enhancement of seedlings growth and surface microorganisms inactivation. Plasma Chem. Plasma Process. 2018, 38, 969–988. [Google Scholar] [CrossRef]
- Starič, P.; Vogel-Mikuš, K.; Mozetič, M.; Junkar, I. Effects of nonthermal plasma on morphology, genetics and physiology of seeds: A review. Plants 2020, 9, 1736. [Google Scholar] [CrossRef] [PubMed]
- Šerá, B.; Gajdová, I.; Černák, M.; Gavril, B.; Hnatiuc, E.; Kováčik, D.; Kříha, V.; Sláma, J.; Šerý, M.; Špatenka, P. How various plasma sources may affect seed germination and growth. In Proceedings of the 2012 13th International Conference on Optimization of Electrical and Electronic Equipment (OPTIM), Brasov, Romania, 24–26 May 2012; pp. 1365–1370. [Google Scholar] [CrossRef]
- Bol’shakov, A.A.; Cruden, B.A.; Mogul, R.; Rao, M.V.V.S.; Sharma, S.P.; Khare, B.; Meyyappan, M. Radio-frequency oxygen plasma as a sterilization source. AIAA J. 2004, 42, 823–832. [Google Scholar] [CrossRef]
- Regvar, M.; Bukovnik, U.; Likar, M.; Kreft, I. UV-B radiation affects flavonoids and fungal colonisation in Fagopyrum esculentum and F. tataricum. Cent. Eur. J. Biol. 2012, 7, 275–283. [Google Scholar] [CrossRef]
- Moreira, A.J.; Mansano, R.D.; De Jesus Andreoli Pinto, T.; Ruas, R.; Da Silva Zambon, L.; Da Silva, M.V.; Verdonck, P.B. Sterilization by oxygen plasma. Appl. Surf. Sci. 2004, 235, 151–155. [Google Scholar] [CrossRef]
- Montie, T.C.; Kelly-Wintenberg, K.; Reece Roth, J. An overview of research using the one atmosphere uniform glow discharge plasma (OAUGDP) for sterilization of surfaces and materials. IEEE Trans. Plasma Sci. 2000, 28, 41–50. [Google Scholar] [CrossRef]
- Laroussi, M. Low temperature plasma-based sterilization: Overview and state-of-the-art. Plasma Process. Polym. 2005, 2, 391–400. [Google Scholar] [CrossRef]
- Chau, T.T.; Kao, K.C.; Blank, G.; Madrid, F. Microwave plasmas for low-temperature dry sterilization. Biomaterials 1996, 17, 1273–1277. [Google Scholar] [CrossRef]
- Kelly-Wintenberg, K.; Montie, T.C.; Brickman, C.; Roth, J.R.; Carr, A.K.; Sorge, K.; Wadsworth, L.C.; Tsai, P.P.Y. Room temperature sterilization of surfaces and fabrics with a one atmosphere uniform glow discharge plasma. J. Ind. Microbiol. Biotechnol. 1998, 20, 69–74. [Google Scholar] [CrossRef]
- Moreau, S.; Moisan, M.; Tabrizian, M.; Barbeau, J.; Pelletier, J.; Ricard, A.; Yahia, L. Using the flowing afterglow of a plasma to inactivate Bacillus subtilis spores: Influence of the operating conditions. J. Appl. Phys. 2000, 88, 1166–1174. [Google Scholar] [CrossRef]
- Kopacki, M.; Pawlat, J.; Terebun, P.; Kwiatkowski, M.; Starek, A.; Kiczorowski, P. Efficacy of non-thermal plasma fumigation to control fungi occurring on onion seeds. In Proceedings of the 2017 International Conference on Electromagnetic Devices and Processes in Environment Protection with Seminar Applications of Superconductors (ELMECO & AoS), Naleczow, Poland, 3–6 December 2017; pp. 1–4. [Google Scholar] [CrossRef]
- Moisan, M.; Barbeau, J.; Moreau, S.; Pelletier, J.; Tabrizian, M.; Yahia, L.H. Low-temperature sterilization using gas plasmas: A review of the experiments and an analysis of the inactivation mechanisms. Int. J. Pharm. 2001, 226, 1–21. [Google Scholar] [CrossRef]
- Philip, N.; Saoudi, B.; Crevier, M.C.; Moisan, M.; Barbeau, J.; Pelletier, J. The respective roles of UV photons and oxygen atoms in plasma sterilization at reduced gas pressure: The case of N2-O2 mixtures. IEEE Trans. Plasma Sci. 2002, 30, 1429–1436. [Google Scholar] [CrossRef]
- Moisan, M.; Barbeau, J.; Crevier, M.; Pelletier, J.; Philip, N.; Saoudi, B. Plasma sterilization. Methods and mechanisms. Pure Appl. Chem. 2002, 74, 349–358. [Google Scholar] [CrossRef]
- Rossi, F.; Kylián, O.; Hasiwa, M. Decontamination of surfaces by low pressure plasma discharges. Plasma Process. Polym. 2006, 3, 431–442. [Google Scholar] [CrossRef]
- Cvelbar, U.; Vujoševič, D.; Vratnica, Z.; Mozetič, M. The influence of substrate material on bacteria sterilization in an oxygen plasma glow discharge. J. Phys. D Appl. Phys. 2006, 39, 3487–3493. [Google Scholar] [CrossRef]
- Vicoveanu, D.; Popescu, S.; Ohtsu, Y.; Fujita, H. Competing inactivation agents for bacterial spores in radio-frequency oxygen plasmas. Plasma Process. Polym. 2008, 5, 350–358. [Google Scholar] [CrossRef]
- Lee, K.; Paek, K.H.; Ju, W.T.; Lee, Y. Sterilization of bacteria, yeast, and bacterial endospores by atmospheric-pressure cold plasma using helium and oxygen. J. Microbiol. 2006, 44, 269–275. [Google Scholar] [PubMed]
- Basaran, P.; Ozcan, M. Occurrence of aflatoxins in various nuts commercialized in Turkey. J. Food Saf. 2009, 29, 95–105. [Google Scholar] [CrossRef]
- Caetano-Anollés, G.; Favelukes, G.; Bauer, W.D. Optimization of surface sterilization for legume seed. Crop. Sci. 1990, 30, 708–712. [Google Scholar] [CrossRef]
- Charkowski, A.O.; Sarreal, C.Z.; Mandrell, R.E. Wrinkled alfalfa seeds harbor more aerobic bacteria and are more difficult to sanitize than smooth seeds. J. Food Prot. 2001, 64, 1292–1298. [Google Scholar] [CrossRef]
- Kalinova, J.; Voženilkova, B.; Moudry, J. Occurrence of Fusarium spp and bacteria on surface of buckwheat achenes (Fagopyrum esculentum Moench). In Proceedings of the 9th International Symposium on Buckwheat, Prague, Czech Republic, 18–22 August 2004; pp. 491–493. [Google Scholar]
- Pastor, F.J.; Guarro, J. Alternaria infections: Laboratory diagnosis and relevant clinical features. Clin. Microbiol. Infect. 2008, 14, 734–746. [Google Scholar] [CrossRef]
- De Hoog, G.S.; Horré, R. Molecular taxonomy of the Alternaria and Ulocladium species from humans and their identification in the routine Molekulare Taxonomie humaner Isolate von Alternaria und Ulocladium -Arten und ihre Identifizierung im Routinelabor. Mycoses 2002, 276, 259–276. [Google Scholar] [CrossRef]
- Woudenberg, J.H.C.; Seidl, M.F.; Groenewald, J.Z.; de Vries, M.; Stielow, J.B.; Thomma, B.P.H.J.; Crous, P.W. Alternaria section Alternaria: Species, formae speciales or pathotypes? Stud. Mycol. 2015, 82, 1–21. [Google Scholar] [CrossRef]
- Stankovic, S.; Levic, J.; Petrovic, T.; Logrieco, A.; Moretti, A. Pathogenicity and mycotoxin production by Fusarium proliferatum isolated from onion and garlic in Serbia. Eur. J. Plant Pathol. 2007, 118, 165–172. [Google Scholar] [CrossRef]
- Kordas, L.; Pusz, W.; Czapka, T.; Kacprzyk, R. The effect of low-temperature plasma on fungus colonization of winter wheat grain and seed quality. Pol. J. Environ. Stud. 2015, 24, 433–438. [Google Scholar]
- Ambrico, P.F.; Šimek, M.; Morano, M.; De Miccolis Angelini, R.M.; Minafra, A.; Trotti, P.; Ambrico, M.; Prukner, V.; Faretra, F. Reduction of microbial contamination and improvement of germination of sweet basil (Ocimum basilicum L.) seeds via surface dielectric barrier discharge. J. Phys. D Appl. Phys. 2017, 50. [Google Scholar] [CrossRef]
- Holc, M.; Primc, G.; Iskra, J.; Titan, P.; Kovač, J.; Mozetič, M.; Junkar, I. Effect of oxygen plasma on sprout and root growth, surface morphology and yield of garlic. Plants 2019, 8, 462. [Google Scholar] [CrossRef]
- Ellis, R.A.; Roberts, E.H. The quantification of aging and survival in orthodox seeds. Seed Sci. Technol. 1981, 9, 373–409. [Google Scholar]
- Farooq, M.; Basra, S.M.A.; Ahmad, N.; Hafeez, K. Thermal hardening: A new seed vigor enhancement tool in rice. J. Integr. Plant Biol. 2005, 47, 187–193. [Google Scholar] [CrossRef]
- Muskett, A.E.; Malone, J.P. The ulster method for the examination of flax seed for the presence of seed—borne parasites. Ann. Appl. Biol. 1941, 28, 8–13. [Google Scholar] [CrossRef]
- Likar, M.; Regvar, M. Isolates of dark septate endophytes reduce metal uptake and improve physiology of Salix caprea L. Plant Soil 2013, 370, 593–604. [Google Scholar] [CrossRef]

| CB | TB | |||
|---|---|---|---|---|
| Treatment | MGT | T50 | MGT | T50 |
| Control | 3.77 a | 1.30 a | 4.01 a | 1.51 a |
| 15 s | 4.26 bc | 1.56 a | 4.71 b | 2.33 ab |
| 30 s | 4.54 cd | 2.41 b | 4.99 b | 2.54 b |
| 45 s | 4.82 d | 2.88 b | 5.17 b | 2.62 b |
| 60 s | 3.98 ab | 2.40 b | 5.86 c | 3.63 c |
| 90 s | n.d. | n.d. | 5.89 c | 3.67 c |
| 120 s | n.d. | n.d. | n.d. | n.d. |
Publisher’s Note: MDPI stays neutral with regard to jurisdictional claims in published maps and institutional affiliations. |
© 2021 by the authors. Licensee MDPI, Basel, Switzerland. This article is an open access article distributed under the terms and conditions of the Creative Commons Attribution (CC BY) license (https://creativecommons.org/licenses/by/4.0/).
Share and Cite
Mravlje, J.; Regvar, M.; Starič, P.; Mozetič, M.; Vogel-Mikuš, K. Cold Plasma Affects Germination and Fungal Community Structure of Buckwheat Seeds. Plants 2021, 10, 851. https://doi.org/10.3390/plants10050851
Mravlje J, Regvar M, Starič P, Mozetič M, Vogel-Mikuš K. Cold Plasma Affects Germination and Fungal Community Structure of Buckwheat Seeds. Plants. 2021; 10(5):851. https://doi.org/10.3390/plants10050851
Chicago/Turabian StyleMravlje, Jure, Marjana Regvar, Pia Starič, Miran Mozetič, and Katarina Vogel-Mikuš. 2021. "Cold Plasma Affects Germination and Fungal Community Structure of Buckwheat Seeds" Plants 10, no. 5: 851. https://doi.org/10.3390/plants10050851
APA StyleMravlje, J., Regvar, M., Starič, P., Mozetič, M., & Vogel-Mikuš, K. (2021). Cold Plasma Affects Germination and Fungal Community Structure of Buckwheat Seeds. Plants, 10(5), 851. https://doi.org/10.3390/plants10050851









